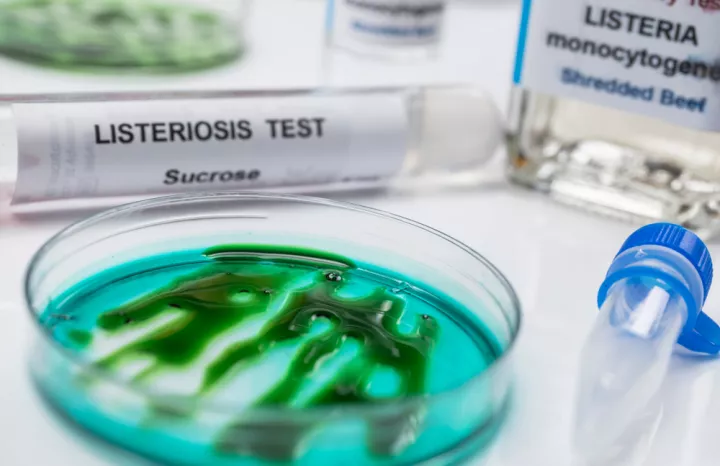
Ραγδαία αύξηση λοιμώξεων από Listeria στην Ευρώπη: Τι δείχνει η νέα μεγάλη έκθεση EFSA – ECDC

Τα τελευταία στοιχεία που δημοσιοποίησαν η Ευρωπαϊκή Αρχή για την Ασφάλεια των Τροφίμων (EFSA) και το Ευρωπαϊκό Κέντρο Πρόληψης και Ελέγχου Νοσημάτων (ECDC) δείχνουν μια ανησυχητική ανοδική τάση στις σοβαρές λοιμώξεις από το βακτήριο Listeria monocytogenes σε ολόκληρη την Ευρωπαϊκή Ένωση και στον ευρύτερο ευρωπαϊκό χώρο - παρά το υψηλό επίπεδο των κανόνων ασφάλειας των τροφίμων. Η νέα ετήσια «One Health Zoonoses Report» (που καλύπτει δεδομένα του 2024) καταγράφει αυξημένα περιστατικά τροφιμογενών λοιμώξεων, με τη Listeria να ξεχωρίζει για τη σοβαρότητα και τη θνητότητά της.
Λιστερίωση: σπάνια αλλά εξαιρετικά σοβαρή
Η λιστερίωση δεν είναι τόσο συχνή όσο άλλες τροφιμογενείς λοιμώξεις, όμως είναι εξαιρετικά επικίνδυνη - ειδικά για ηλικιωμένους, εγκύους, νεογνά και ανοσοκατεσταλμένα άτομα. Θεωρείται μία από τις πιο σοβαρές λοιμώξεις που μεταδίδονται μέσω τροφής.
Σύμφωνα με την έκθεση: Το 2024, η Listeria προκάλεσε τον υψηλότερο αριθμό νοσηλειών και θανάτων από όλες τις καταγεγραμμένες λοιμώξεις από τρόφιμα στην ΕΕ.
Περίπου 7 στους 10 ασθενείς μολύνθηκαν σοβαρά και χρειάστηκαν νοσηλεία, ενώ 1 στους 12 κατέληξε.
Ακόμη κι αν τα συνολικά επίπεδα μόλυνσης στα τρόφιμα παραμένουν χαμηλά σε όλη την Ευρώπη (με μόλις έως περίπου 3% των δειγμάτων έτοιμων προϊόντων να υπερβαίνουν τα όρια ασφαλείας), η βακτηριακή λοίμωξη παραμένει κρίσιμη λόγω του υψηλού ποσοστού σοβαρών περιπτώσεων.
Τι δείχνουν οι αριθμοί
Σύμφωνα με τα στοιχεία της EFSA και του ECDC, ο αριθμός των επιβεβαιωμένων κρουσμάτων λιστερίωσης το 2024 ξεπέρασε τους 3.000 και βρίσκεται στα υψηλότερα επίπεδα που έχουν καταγραφεί στη σύγχρονη εποχή της ευρωπαϊκής επιτήρησης.
Η αύξηση αυτή συνδέεται με παράγοντες όπως η γήρανση του πληθυσμού (με περισσότερους ανθρώπους ευάλωτους σε σοβαρή νόσο), η αλλαγή στις διατροφικές συνήθειες (πιο συχνή κατανάλωση έτοιμων προς κατανάλωση τροφίμων), καθώς και η μη ορθή διαχείριση ή αποθήκευση τροφίμων στο σπίτι ή στην αλυσίδα παραγωγής.
Τρόφιμα και πηγές κινδύνου
Τα τρόφιμα που συχνότερα συνδέονται με επιμόλυνση από Listeria περιλαμβάνουν:
- προϊόντα έτοιμα προς κατανάλωση
- αλλαντικά
- προϊόντα με βάση το κρέας και τα ψάρια
Παρότι η συχνότητα μόλυνσης είναι χαμηλή, η λοίμωξη που προκαλεί το βακτήριο μπορεί να είναι πολύ σοβαρή – γι’ αυτό και παραμένει ένα από τα βασικά σημεία επιτήρησης στις εκθέσεις της EFSA και του ECDC.
Τι αλλάζει στην επιτήρηση
Η τελευταία έκθεση δεν αναδεικνύει μόνο αυξημένα κρούσματα. Είναι επίσης ενδεικτική μιας τάσης που παρατηρείται τα τελευταία χρόνια, με πιο συχνή εμφάνιση λοιμώξεων που απαιτούν νοσηλεία και έχουν υψηλότερη θνητότητα. Ειδικά σε χώρες όπου το δημογραφικό γηράσκει και οι διατροφικές επιλογές περιλαμβάνουν περισσότερα προπαρασκευασμένα προϊόντα, οι αρχές θεωρούν ότι χρειάζεται αυξημένη προσοχή στις πρακτικές ασφάλειας τροφίμων παντού - από το εργοστάσιο μέχρι το σπίτι.
Η μάχη κατά των λοιμώξεων συνεχίζεται
Παρά τη σοβαρότητα των ευρημάτων, η EFSA και το ECDC τονίζουν ότι τα μέτρα ασφάλειας τροφίμων στην ΕΕ παραμένουν ισχυρά και ότι η πλειονότητα των προϊόντων που κυκλοφορούν στην αγορά είναι ασφαλή. Ωστόσο, η αναφορά υπογραμμίζει την ανάγκη για:
- ενισχυμένη επιτήρηση σε όλη την αλυσίδα τροφίμων
- συνεχή εκπαίδευση για σωστή υγιεινή και αποθήκευση τροφίμων
- στοχευμένες δράσεις για ευάλωτες ομάδες του πληθυσμού.
Τι σημαίνουν αυτά για τον πολίτη
H τελευταία έκθεση EFSA – ECDC αποτελεί μια σοβαρή προειδοποίηση: η λιστερίωση μπορεί να είναι σπάνια, αλλά όταν εμφανίζεται, είναι ένας από τους πιο επικίνδυνους παράγοντες τροφικής νόσησης. Η ενημέρωση, η σωστή διαχείριση τροφίμων στο σπίτι και μια καλά οργανωμένη επίβλεψη από τις αρχές παραμένουν κρίσιμες για τη δημόσια υγεία στην Ευρώπη.